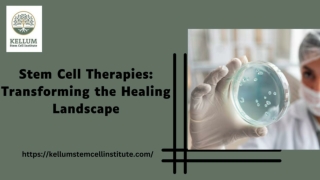
Stem Cell Therapies: Transforming the Healing Landscape

Kellum Stem Cell Institute
, Kellum Stem Cell Institute
At Kellum Stem Cell Institute, we harness the incredible potential of stem cells to promote organic recovery and alleviate pain. Our therapeutic solutions stand as compelling alternatives to surgical interventions and prolonged reliance on medications.
- 26 Presentations
- United States
- https://kellumstemcellinstitute.com
- Rejoint 01/10/2024